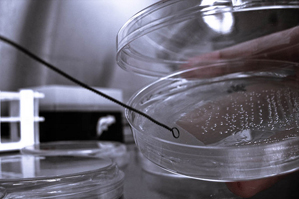

A new age for drug discovery
In the last fifty years, pharmaceutical companies have spent tens of billions of dollars trying to find new classes of antibiotic drugs. Only one has made it into clinical practice. Seem surprising to you? Yeah, me too.
At the same time, antibacterial resistance has been rising, meaning the pathogens that infect us are getting better and better at staying alive. If we continue like this, said biology professor Kim Lewis, “we’ll go back to the age of epidemics and pandemics…society is at risk.”
The standard approach for facilitating drug discovery has been to pump more money into the system. “But this is not about a lack of money,” Lewis said. “It’s the paucity of ideas, not money, that did in this field.”
In today’s issue of Nature magazine Lewis’ essay “Recover the lost art of drug discovery” lays out a clear roadmap for what went wrong in the field, what worked and where we should go from here.
During the “golden age” of antibiotic discovery in the 1940s, the primary approach, invented by Selman Waksman, was to screen soil microbes for their ability to produce natural antibiotics. Large pharmaceutical companies got rich with this method, Lewis said. But over time the approach collapsed: the same compounds emerged over and over again. As it turned out, only tiny fraction of all bacteria could be cultivated in the lab.
In a 2002 article in Science, Lewis and professor Slava Epstein presented a novel strategy for cultivating previously uncultivated bacteria. “The idea was to grow bacteria in their natural environment,” Lewis explained. This strategy opened the door for revitalizing the Waksman platform, which had previously been useless for 99 percent of bacteria, the so-called “uncultivable” bacteria. Their teams at NU are now collaborating with NovoBiotic, a Biotech startup in Cambridge, MA, that licensed this invention, to discover novel antibiotics from previously uncultured bacteria.
The 1940s and 50s also saw the heyday for synthetic antibiotic discovery. “When the Waksman platform collapsed, the industry came up with two new logical approaches,” Lewis said. First was rational design, in which synthetic chemists created new compounds that specifically targeted the proteins inside pathogens based on their molecular structures. These failed, however, because they were incapable of penetrating the complex bacterial cell envelope.
The second approach was high-throughput screening, which tests thousands of synthetic compounds in parallel for their targeting abilities. Again, the difficulty of penetration prevented this otherwise extremely successful method from gaining traction in the antibiotic discovery field, said Lewis.
In his essay, Lewis proposes to establish a set of “rules for penetration.” He suggests characterizing 100 or so compounds that are capable of penetrating the bacterial envelope (regardless of antibiotic activity) and teasing out the common properties that seem to be important for penetration. “We can then build a library of compounds which takes these new rules into account,” he said. “Then, if you are rationally designing an inhibitor you can also put into it properties that you know are essential for penetration.”
In the first sentence of the essay, Lewis says “the more we know about antibiotics, the fewer we can discover.” The problem, he explained, is that every time the industry has tried to improve, it has done so based on imperfect knowledge. Lewis believes we have finally come full circle, and are now in a position to revitalize the lost art of drug discovery. He is working on a second article geared toward fellow microbiologists that will outline the scientific requirements to make his vision a reality.